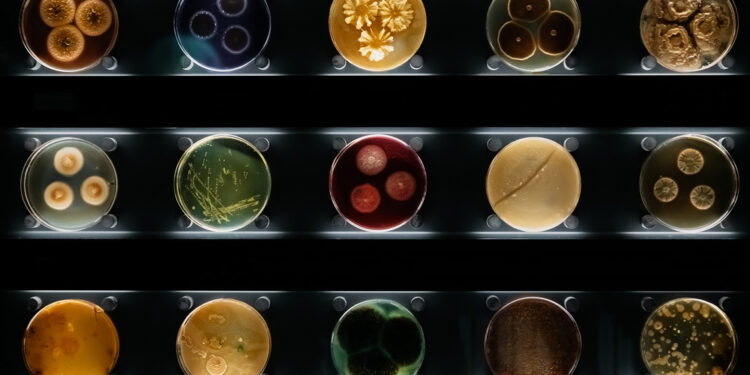
KRE infekcija: priežastys, simptomai, diagnostika ir gydymas

Carbapenemui atsparūs enterobakteralai (CRE) – tai bakterijų grupė, kuri dėl savo atsparumo vienam iš svarbiausių antibiotikų tipų, vadinamų karbapenemais, tapo dideliu iššūkiu medicinoje. Tokios bakterijos dažnai sukelia įvairias infekcijas, o jų gydymas tampa sudėtingesnis, nes įprastai skiriami antibiotikai prieš jas dažnai neveiksmingi.
Kas yra CRE?
Enterobakteralai – tai plačiai paplitusi bakterijų grupė, kuri apima keletą šeimų. Svarbiausi jos atstovai yra Escherichia coli ir Klebsiella pneumoniae. Būtent šios bakterijos dažniausiai įgyja atsparumą karbapenemams, todėl tokios padermės vadinamos CRE – karbapenemui atspariais enterobakteralais. Vis dėlto, ne kiekvienas E. coli ar Klebsiella atvejis yra atsparus antibiotikams.
Karbapenemai, kuriems šios bakterijos tampa atsparios, apima tokius vaistus kaip ertapenemas, imipenemas ir meropenemas. Kai kurios CRE padermės sugeba išskirti karbapenemazes – fermentus, kurie suskaldo karbapenemus, todėl jie tampa neveiksmingi gydant infekcijas.
Kur atsiranda CRE infekcijos ir kuo jos pavojingos?
CRE bakterijos gali sukelti įvairių kūno vietų infekcijas. Dažniausiai infekuojama kraujas, šlapimo takai, plaučiai (sukeliant pneumoniją), pilvo ertmė ar žaizdų vietos. Gydymui įprasti antibiotikai dažnai neveikia, todėl esant sunkioms infekcijoms gresia pavojingos komplikacijos ir organų pažeidimai.
Kiek paplitusios CRE infekcijos?
Kai kuriose šalyse kasmet užregistruojama tūkstančiai infekcijų, o mirštamumas, priklausomai nuo infekcijos vietos, gali siekti ir pusę atvejų – ypač, jei infekcija plinta į kraują.
CRE simptomai
Pasireiškiantys simptomai priklauso nuo to, kuri kūno vieta paveikta infekcijos. Įprasti požymiai gali būti:
- Karščiavimas
- Šaltkrėtis
- Dusulys arba kosulys
- Pilvo skausmas
- Skausmingas šlapinimasis
- Paraudimas, tinimas ar niežėjimas žaizdos vietoje ar po operacijos
Daugelis šių simptomų gali būti būdingi ir kitoms infekcijoms, todėl negalima vien pagal juos tiksliai nustatyti ligos priežasties.
Kas lemia CRE atsiradimą?
Bakterijų atsparumas antibiotikams kyla dėl ilgalaikio šių vaistų vartojimo ar pernelyg plataus naudojimo, ypač ligoninėse ar slaugos namuose. Tokiose vietose bakterijos dažnai susiduria su antibiotikais, o ilgainiui tarp jų išplinta atsparumą sąlygojančios genetinės savybės.
Bakterijos „moko“ viena kitą būti atspariomis – jos gali keistis genetine informacija, greitai perduoti „atsparumo geną“ kitoms bakterijoms ir išlikti gyvybingos net po gydymo. Vienas iš dažniausių atsparumo mechanizmų – bakterijos pradeda gaminti specialius fermentus, kurie suardo karbapenemus ir kiti antibiotikai praranda poveikį.
Kaip plinta CRE?
Kai kurie žmonės gali nejausti jokių ligos požymių, nors jų organizme ar ant odos jau gyvena CRE bakterijos – tai vadinama kolonizacija. Tokie asmenys, net ir nesirgę, gali perduoti bakterijas kitiems.
Dažniausiai užsikrečiama gydymo įstaigose – ligoninėse ir slaugos namuose, kur bakterijos ilgiau kontaktuoja su antibiotikais. CRE galima gauti nuo:
- Kontakto su bakteriją turinčiu žmogumi (ypač neplaunant rankų)
- Užterštų paviršių, ypač vonios kambariuose ar tose vietose, kur yra kriauklių bei tualetų
- Užterštų medicinos prietaisų, pavyzdžiui, kateterių, kvėpavimo vamzdelių
Didesnės rizikos grupės
- Žmonės, kuriems yra įdėti medicininiai prietaisai: kateteriai, kvėpavimo ar maitinimo vamzdeliai (tai sudaro sąlygas patekti bakterijoms į organizmą iš aplinkos)
- Tie, kurie vartoja ar vartojo antibiotikus ilgą laiką (kuo ilgiau, tuo labiau silpsta „geroji“ žarnyno mikroflora, o patogeninės bakterijos lengviau išplinta)
- Asmenys, turintys silpnesnę imuninę sistemą dėl lėtinių ligų, pavyzdžiui, sergantiems cukriniu diabetu ar vėžiu, po organų ar kraujo kamieninių ląstelių transplantacijos
- Žmonės, kuriems reikia nuolatinės pagalbos kasdienėje veikloje bei tiems, kurie dažniau kontaktuoja su kitų žmonių kūno skysčiais, ypač slaugos įstaigose
- Ilgai besigydantys ligoninėse, ypač jei buvo hospitalizuoti kitose šalyse, kur CRE dar dažnesnės
Komplikacijos
Jei bakterijų sukelta infekcija negali būti sustabdyta net ir naudojant antibiotikus, gresia sunkios pasekmės: infekcija gali išplisti po visą organizmą, paveikti gyvybiškai svarbius organus ir tapti mirtina.
Diagnozės nustatymas
Jei įtariama bakterinė infekcija, kuri nedingsta gydant antibiotikais, gydytojas paskiria atitinkamus tyrimus. Dažniausiai tiriami šie mėginiai:
- Kraujas
- Šlapimas
- Išmatos
- Žaizdos skysčiai ar audinių mėginiai
Laboratorija gali nustatyti, kokios konkrečios bakterijos sukėlė infekciją ir ar jos yra atsparios karbapenemams. Labai svarbu gydytojui pranešti, jei paskutinėmis savaitėmis buvote gydytas ligoninėje arba jums yra implantuoti medicininiai prietaisai.
Gydymas
KRE sukeltos infekcijos labai sunkiai gydomos, nes dauguma įprastų antibiotikų jų neveikia. Gydytojai dažnai renkasi kitokį antibiotikų derinį ar naudoja karbapenemą kartu su vaistu, blokuojančiu bakterijų fermentą. Laboratorijoje gali būti tiriamas įvairių vaistų poveikis būtent jūsų bakterijos atmainai.
Dažniausiai naudojami antibiotikai
- Polimiksinai (arba kolistinas)
- Tigeciklinas
- Fosfomicinas
- Aminoglikozidai (gentamicinas, tobramicinas)
- Rifampinas
- Karbapenemai, derinami su fermentų inhibitoriais
Prevencija – kaip sumažinti CRE plitimą?
Medicinos darbuotojai, kad sumažintų tokių infekcijų riziką, nuolat laikosi higienos ir sterilizavimo taisyklių. Svarbiausi prevencijos būdai:
- Rankų plovimas ir dezinfekavimas
- Paviršių dezinfekcija
- Antibiotikų skyrimas tik tuomet, kai jie iš tiesų reikalingi
- Medicinos priemonių sterilizacija
Savo sveikatą galite apsaugoti dažnai plaudami rankas, ypač jei slaugote žmogų, kurio imunitetas silpnesnis ar kuris reikalauja daug pagalbos kasdienėje veikloje. Taip pat svarbu pasiklausti gydytojo, kiek laiko būsite prijungti prie gydymo prietaisų bei kaip geriausiai sumažinti infekcijos riziką jų naudojimo metu.
Kaip sunkios yra CRE infekcijos?
KRE bakterijos gali sukelti labai sunkias, sunkiai gydomas ligas. Ypač didelė grėsmė kyla, kai išsivysto kraujo užkrėtimas ar infekcija plinta per visą kūną. Tokiais atvejais gydymas gali vykti tik stacionare, nuolat stebint profesionalams.
Mirties rizika nuo CRE priklauso nuo infekcijos vietos – nuo kiek lengvesnių šlapimo takų infekcijų iki itin pavojingo sepsio. Statistika rodo, jog sudėtingiausiais atvejais mirtingumas siekia 50 % ar daugiau.
Gyvenimas su padidinta rizika
Jei jums implantuotas medicininis prietaisas, imuninė sistema nusilpusi ar esate gydytas ligoninėje, verta su gydytoju aptarti konkrečius požymius, kurie galėtų signalizuoti apie infekciją. Nuolat stebėkite savo savijautą ir, atsiradus neįprastiems simptomams, nedelskite kreiptis pagalbos.
Net ir gydantis ligoninėje, itin svarbus atviras bendravimas su medikais. Nedvejodami informuokite juos apie tokius simptomus kaip stiprus skausmas, dažnas pulsas, silpnumas ar temperatūra.
Kada reikalinga skubi medicininė pagalba?
- Kai temperatūra viršija 40°C
- Stiprus, nepakeliamas skausmas
- Traukuliai
- Staigus sumišimas ar dezorientacija
- Kraujospūdžio kritimas su silpnumu ar alpimu
Klausimai, kuriuos verta užduoti savo gydytojui
- Kokios gydymo galimybės galimos mano atveju?
- Kiek laiko gali trukti gydymas ir kaip greitai turėčiau pasijusti geriau?
- Iš kur galėjau užsikrėsti infekcija?
- Ką daryti, kad ateityje sumažinčiau tokios infekcijos riziką?